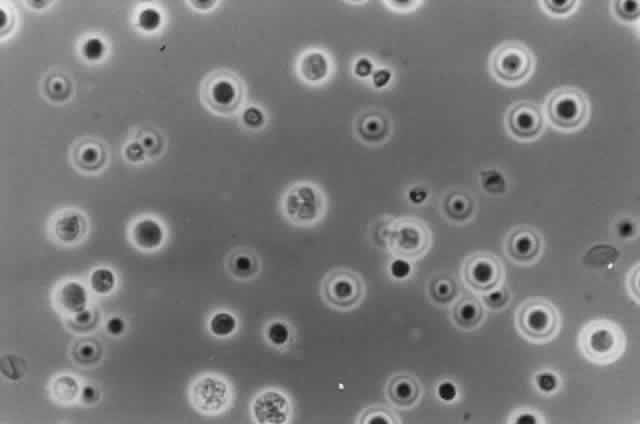

HYPHOMYCETES (HYALINE FUNGI)
ACREMONIUM SPECIES (CEPHALOSPORIUM SPECIES).
Growth matures within 2 to 6 days. Colonies are white, pink, or gray. Reverse is colorless, pale yellow, or pinkish. Texture is moist, spreading, becoming woolly with age. Microscopic findings include slender, delicate septated hyphae. Conidiophores are simple and erect with one-celled, occasionally two-celled, conidia arranged in clusters at the tips.
ASPERGILLUS SPECIES.
Growth matures within 2 to 6 days. Colonies are white, blue green, green, yellow, brown, or black. Reverse is white, gold, or brown. Colonies are flat, wrinkled or furrowed, with a velvety or cottony texture. Microscopic findings include large, septated hyphae. Simple, unbranched conidiophores arise from a foot cell and are enlarged at the tip (vesicle). Each conidiophore is covered partially or completely with one or two rows of flask-shaped phialides with chains of conidia (Fig. 1).
|
FUSARIUM SPECIES.
Growth matures within 2 to 6days. Colonies are white, blue, pink, purple, yellow, or green. Reverse is light in color. Texture is fluffy to woolly. Microscopic findings include small septated hyphae. Conidiophores are simple and either long or short, branched or unbranched. They produce single- or two-celled oval to cylindric microconidia (Fig. 2). Large banana-shaped multiseptated macroconidia are produced on potato dextrose agar in 4 to 6 weeks (Fig. 3). Chlamydospores may be numerous or rare.
|
|
MONILIA SITOPHILA.
Growth matures within 2 to 6 days. Colonies are white, then become salmoncolored. Microscopic findings include septated hyphae. Conidiophores produce branching chains of oval conidia, which are produced by continuous budding. Arthrospores are formed when the older hyphae break up.
PAECILOMYCES SPECIES.
Growth matures within 2 to 6 days. Colonies are white, pink, violet, yellowish brown, or greenish gold. Reverse is white to brown. Colonies spread and have a granular to velvety texture. Microscopic findings include slender delicate hyphae. Conidiophores are septated and have phialides with elongated necks containing long chains of small elliptic or oblong conidia (a penicillus).
PENICILLIUM SPECIES.
Growth matures within 2 to 6 days. Colonies are white, any shade of green to blue-green, pink, tan, yellow, or orange. Reverse is usually white but may be red or brown due to a diffusible pigment. Colonies are wrinkled with a velvety or granular texture. Microscopic findings include septated hyphae. Conidiophores are either unbranched or branched. The branches are termed metulae and they bear the flask-shaped phialides which contain the unbranched chains of either smooth or rough, round conidia. This entire structure--the metula, phialides and conidia--form the “penicillus.”
VERTICILLIUM SPECIES.
Growth matures in 2 to 6days. Colonies are first white, then become pinkish brown, red, green, or yellow. Reverse is either white or rust. Colony texture is either powdery or velvety. Microscopic findings include septated hyphae. Conidiophores are erect, simple or branched at several levels, and occur in whorls. Flask-shaped phialides arise from the apex of the branches. Conidia are single celled, oval to cylindrical, and appear singly or in clusters at the ends of the phialides.
DEMATIACEOUS FUNGI
ALTERNARIA SPECIES.
Growth matures within 2 to 6 days. Colonies are gray, grayish white, grayish green, grayish brown, or brown to greenish black with a light gray to white border. The reverse is black. Texture is woolly. Microscopic findings include golden brown to dark brown septated hyphae. Conidiophores are dark brown and septated. Conidia are dark brown, muriform with horizontal and longitudinal septa and are formed in long chains (Fig. 4).
|
AUREOBASIDIUM PULLULANS (PULLULARIA PULLULANS).
Growth matures within 6 to 10 days. Colonies are at first white, they become black, shiny, and leathery with a grayish edge as the colony matures. The reverse is black. Microscopically, two types of hyphae are produced. The first type is hyaline, thin walled, and produces hyaline single-celled conidia directly from the hyphal wall. The second type is darkly pigmented, thick walled, closely septated, and produces hyaline single-celled conidia that arise from short projections (denticles) from the hyphal wall.
CLADOSPORIUM SPECIES.
Growth matures within 6to 10 days. Colonies are grayish green to dark olive, folded and heaped with a velvety texture. Reverse is black or dark brown. Most species are not capable of growing at 35 °C. Microscopic findings include dark brown septated hyphae. Conidiophores are branched with chains of budding conidia. Conidia are one celled with distinct scars on their ends (disjunctors). The large cells which bear the chains of conidia resemble shields (“shield cells”) when they are seen by themselves.
CURVULARIA SPECIES.
Growth matures within 2 to 6 days. Colonies are dark olive green or grayishbrown, becoming brown to black with a pinking gray surface. Reverse is dark brown to black. Texture is woolly. Microscopic findings include dark brown septated hyphae. Conidiophores are brown, septated, simple or branched, solitary or in groups. Conidia are pale to dark brown, usually curved, occasionally straight, and contain 2 to 6 septa with the first and last cell being lighter that the rest of the cells. One of the segments may be larger than the other segments giving the conidium a bent appearance (Fig. 5).
|
DRESCHLERA SPECIES.
Growth matures within 2 to 6 days. Colonies are gray to black. Reverse is dark. Texture is velvety. Microscopically, brown septated hyphae are seen. Conidiophores are septated, brown, and twisted. The conidia are large, multiseptated, and cylindric and are produced in a zigzag fashion.
HELMINTHOSPORIUM SPECIES.
Growth matureswithin 2 to 6 days. Colonies are dark gray to black. Reverse is black. The texture is cottony to velvety. Microscopic findings include brown septated hyphae. Conidiophores are septated, brown to dark brown, erect, and parallel walled. Conidia are pale to dark brown, obclavate (widest at their base), usually containing more than six cells, and are produced laterally on the conidiophores.
ZYGOMYCETES
ABSIDIA SPECIES.
Growth matures within 1 to 5days. Colonies are white, later becoming gray. Reverse is white. Texture is coarse, woolly, cottony, resembling gray “cotton candy.” Microscopically are seen wide, aseptate, or rarely septated hyphae with rhizoids produced between the sporangiophores (internodal). The sporangiophores are branched and widen just below the sporangia. A septum is present below the sporangium. When the sporangium wall ruptures, the sporangiospores are released, and a short collarette remains on the sporangiophore. The sporangiospores are one celled, ovoid to slightly pear-shaped, smooth and hyaline to light black.
MUCOR SPECIES.
Growth matures within 1 to 4 days.Colonies are white, later becoming brown to black. Reverse is white. Texture is cottony, resembling “cotton candy.” Microscopic findings include wide aseptate, rarely septate, hyphae without rhizoids or stolons. Sporangiophores are long, often branched with a large spheric sporangium. A collarette may be present after the sporangium ruptures. Sporangiospores are smooth, round, or ellipsoid.
RHIZOPUS SPECIES.
Growth matures within 1 to 4days. Colonies are white, later becoming gray or yellowish brown. Reverse is white. Texture is woolly, cottony, resembling “cotton candy.” Pathogenic species are capable of growing at 35°C. Microscopic findings include wide aseptate, rarely septate, hyphae with rhizoids produced directly below the sporangiophore. Sporangiophores are long and unbranched with dark globose sporangia. No collarette is present after the sporangium ruptures. Sporangiospores are one celled, ovoid, smooth to roughened and hyaline to brown (Fig. 6).
|
SYNCEPHALASTRUM SPECIES.
Growth matures within 1 to 4 days. Colonies are white, later becoming dark gray to black. Reverse is white. Texture is woolly or cottony (“cotton candy”). Microscopically are seen wide aseptate, rarely septated, hyphae. Sporangiophores are short, branched with globose vesicles at their tips. Tubular sporangia containing sporangiospores are attached. Rhizoids may be present. Syncephalastrum species may be confused with Aspergillus species but can be separated based on the tubular sporangia and the absence of phialides.